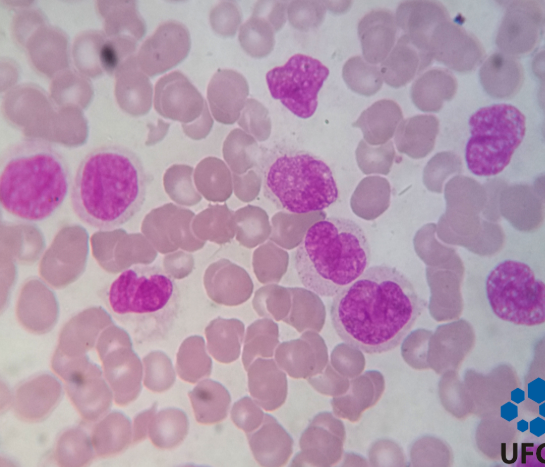
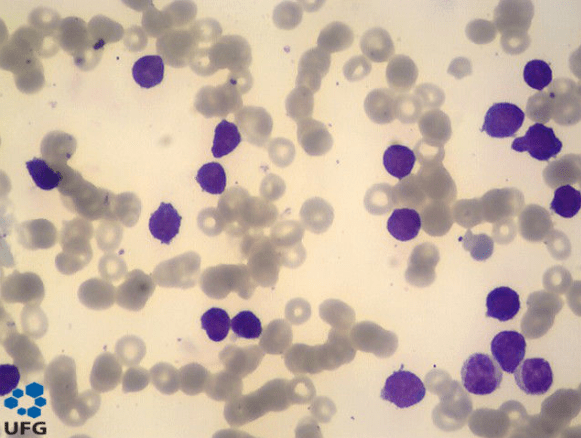

O que é leucemia?
A leucemia é uma neoplasia hematológica caracterizada pela proliferação desordenada de leucócitos anormais, originados principalmente na medula óssea. Essas células imaturas substituem as células sanguíneas normais, prejudicando funções essenciais como oxigenação tecidual, defesa imunológica e coagulação.
Do ponto de vista clínico e biológico, os tipos de leucemia são classificados com base em dois critérios principais:
- Velocidade de progressão da doença (aguda ou crônica)
- Linhagem celular acometida (mieloide ou linfoide)
Essa combinação origina os quatro principais tipos de leucemia primária.
Leucemia mieloide aguda (LMA)
A leucemia mieloide aguda é uma doença de evolução rápida e agressiva, marcada pelo acúmulo de mieloblastos na medula óssea, com possível liberação dessas células para o sangue periférico.
Principais características da LMA:
- Progressão rápida
- Insuficiência medular (anemia, trombocitopenia e neutropenia)
- Maior incidência em adultos e idosos
- Associação com fatores como benzeno, radiação ionizante, quimioterapia prévia e síndromes genéticas
Atualmente, a classificação da LMA leva em conta alterações citogenéticas e moleculares, fundamentais para definição prognóstica e terapêutica.

Imagem: Mieloblasto https://hematologia.farmacia.ufg.br/p/7052-mieloblasto
A LMA foi classificada pelo sistema FAB (Franco-Americano-Britânico), com base na morfologia e grau de maturação celular.
Classificação FAB da LMA
- M0 – LMA com diferenciação mínima
- M1 – LMA sem maturação
- M2 – LMA com maturação
- M3 – Leucemia promielocítica aguda
- M4 – Leucemia mielomonocítica aguda
- M4 com eosinofilia
- M5 – Leucemia monocítica aguda
- M5a (monoblástica)
- M5b (monocítica)
- M6 – Eritroleucemia
- M7 – Leucemia megacarioblástica aguda
Esses subtipos apresentam diferenças morfológicas importantes, como presença de bastonetes de Auer, grau de granulação citoplasmática e envolvimento de diferentes linhagens celulares.

https://hematologia.farmacia.ufg.br
Classificação da OMS para LMA
A Organização Mundial da Saúde incorporou alterações genéticas e clínicas à classificação da LMA:
LMA com alterações citogenéticas recorrentes
- LMA com t(8;21)
- LMA com t(15;17)
- LMA com inv(16) ou t(16;16) (com eosinófilos anormais)
- LMA com anormalidade 11q23
LMA com displasia multilinhagem
- Com antecedente de síndrome mielodisplásica
- Sem antecedente de síndrome mielodisplásica
LMA e SMD associadas à terapia
- Associadas a agentes alquilantes
- Associadas a epipodofilotoxinas
- Outros tipos
LMA não especificada em outros grupos
- LMA minimamente diferenciada
- LMA sem maturação
- LMA com maturação
- LMA com diferenciação monocítica
- Eritroleucemia
- Leucemia megacarioblástica
- Leucemia basofílica aguda
- Panmielose aguda com mielofibrose
Leucemia mieloide crônica (LMC)
A leucemia mieloide crônica é uma neoplasia clonal caracterizada pela proliferação excessiva de granulócitos em diferentes estágios de maturação.
O que diferencia a LMC:
- Evolução lenta
- Presença do cromossomo Philadelphia (gene BCR-ABL)
- Diagnóstico frequente em exames de rotina
- Divisão em três fases: crônica, acelerada e crise blástica
Na fase crônica, muitos pacientes são assintomáticos, o que reforça a importância da interpretação adequada do hemograma.
Leucemia linfoide aguda (LLA)
A leucemia linfoide aguda é caracterizada pela proliferação de linfoblastos imaturos da linhagem B ou T. É o tipo mais comum de leucemia na infância, mas também pode ocorrer em adultos.
Características clínicas da LLA:
- Instalação rápida
- Predomínio em crianças entre 2 e 5 anos
- Manifestações de falência medular
- Necessidade de imunofenotipagem para definição da linhagem
A correta subclassificação da LLA é essencial para o prognóstico e escolha do protocolo terapêutico.

Imagem: Linfoblasto https://hematologia.farmacia.ufg.br/p/7067-linfoblasto
LLA – subtipos
A LLA é caracterizada pela proliferação de linfoblastos imaturos e também foi classificada pelo sistema FAB, com base em critérios morfológicos.
Classificação FAB da LLA
- LLA-L1
- Células pequenas e homogêneas
- Núcleo regular, cromatina frouxa
- Alta relação núcleo/citoplasma
- LLA-L2
- Células grandes e heterogêneas
- Núcleo irregular, nucléolos visíveis
- Baixa relação núcleo/citoplasma
- LLA-L3 (tipo Burkitt)
- Células grandes e homogêneas
- Citoplasma intensamente basofílico e vacuolizado
- Associada à linhagem B
Além da morfologia, a LLA é atualmente subclassificada por imunofenotipagem em:
- LLA-B
- LLA-T
Imagem: LLA https://hematologia.farmacia.ufg.br/p/7148-leucemia-linfoide-aguda-sangue-periferico
Leucemia linfoide crônica (LLC)
A leucemia linfoide crônica é uma doença de curso indolente, caracterizada pelo acúmulo de linfócitos B maduros, porém funcionalmente incompetentes.
Aspectos importantes da LLC:
- Maior prevalência em idosos
- Curso assintomático inicial em muitos casos
- Linfocitose persistente no hemograma
- Presença de sombras de Gumprecht no esfregaço
O estadiamento clínico (Rai e Binet) auxilia na avaliação prognóstica e na decisão terapêutica.
Por que entender os tipos de leucemia é fundamental?
Cada tipo de leucemia apresenta comportamento clínico, resposta ao tratamento e prognóstico distintos. Por isso, a classificação correta da leucemia, baseada na integração entre hemograma, morfologia, imunofenotipagem e citogenética, é essencial para o diagnóstico precoce e manejo adequado do paciente.
O reconhecimento dessas diferenças é indispensável tanto na prática clínica quanto na formação de profissionais da área da saúde.
Por que esse texto é importante? Quero trazer um estudo de caso de uma leucemia especifica, mas antes de publicar esse texto eu preciso que você entenda as leucemias e a imunofenotipagem.
Até a próxima!
Referências bibliográficas
- PUGGINA, Déborah Amaral Barcellos. Um panorama geral sobre as leucemias. Biomédica. Pós-graduanda em Hematologia. Instituto Naoum de Hematologia, São José do Rio Preto – SP.
Disponível em: http://www.ciencianews.com.br/arquivos/ACET/IMAGENS/biblioteca-digital/hematologia/serie_branca/leucemias_linfomas_mieloma/leucemias/72.pdf. - FERNANDES, Maria Fernanda Lourenço. Leucemia: uma revisão da literatura. Trabalho de Conclusão de Curso (Graduação em Ciências Biológicas – Modalidade Médica). Pontifícia Universidade Católica de Goiás, Goiânia, 2024.
- INSTITUTO NACIONAL DO CÂNCER (INCA). Leucemia.
Disponível em: https://www.gov.br/inca/pt-br/assuntos/cancer/tipos/leucemia. - NAOUM, Flávio Augusto; NAOUM, Paulo Cesar. Hematologia Laboratorial – Leucócitos. 3. ed. São José do Rio Preto: Academia de Ciência e Tecnologia, 2015.
Pra citar no seu trabalho escolar:
SOUZA, Debora. Tipos de leucemia: classificação, características e diferenças clínicas. Entre Lâminas, 2026. Disponível em: <https://www.entrelaminas.com.br>. Acesso em: dia mês ano.

Deixe um comentário